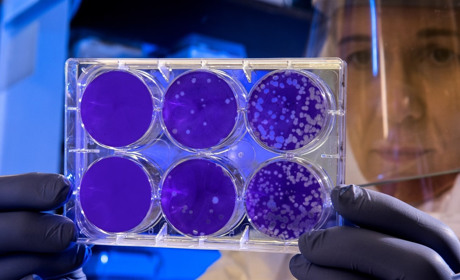
В Україні вводиться загальнонаціональний карантин. Що ще потрібно знати сватівчанам

Сватівчани можуть відслідковувати поширення коронавірусу в Україні і світі онлайн
Якщо чесно — не треба сприймати це дуже із сарказмом, адже кожен із нас може заразитися
14 березня 2020
2608

В Україні зафіксували першу смерть від коронавірусу. Яка ситуація у Сватовому
Дитсадки і школи на карантині
13 березня 2020
3223
В Україні вводиться загальнонаціональний карантин. Що ще потрібно знати сватівчанам
П’ять заходів, які пропонує Уряд для попередження епідемії коронавірусу в Україні
11 березня 2020
4173
Популярні новини
Вибір редакції




